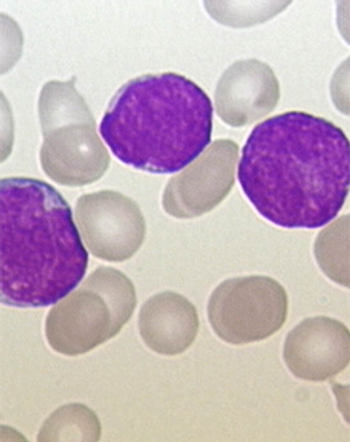

Early consolidation therapy with brentuximab vedotin after autologous stem cell transplant improved progression-free survival of patients with Hodgkin lymphoma.

Your AI-Trained Oncology Knowledge Connection!


Early consolidation therapy with brentuximab vedotin after autologous stem cell transplant improved progression-free survival of patients with Hodgkin lymphoma.

A single cycle of blinatumomab resulted in complete minimal residual disease response in 78% of patients with acute lymphoblastic leukemia.

An oral inhibitor of isocitrate dehydrogenase 2 (IDH2), AG-221, has shown activity and potentially durable remissions in patients with acute myeloid leukemia.

In this video from the 2014 ASH Annual Meeting, Dr. Röllig discusses the results of the SORAML trial that tested sorafenib in patients with acute myeloid leukemia.

Adding carfilzomib to lenalidomide and dexamethasone resulted in a higher PFS and better overall quality of life for relapsed multiple myeloma patients.

The anti–PD-1 (programmed death 1) antibody nivolumab has shown activity in patients with hematologic cancers who have failed three or more prior therapies.

The anti-PD-1 drug pembrolizumab demonstrated promising anti-tumor activity in patients with heavily pretreated classic Hodgkin lymphoma.

Sorafenib proved to have a high level of efficacy in younger acute myeloid leukemia patients, improving both event- and relapse-free survival over placebo.

T-lymphoblastic leukemia (T-ALL) should no longer be considered a poor-risk disease in the pediatric population, according to data presented at ASH.

In this podcast from the 2014 American Society of Hematology Annual Meeting, we discuss some of the new developments in multiple myeloma.

The FDA has approved blinatumomab (Blincyto) for the treatment of patients with Philadelphia chromosome-negative precursor B-cell acute lymphoblastic leukemia.

Early trial data support further evaluation of ixazomib combined with lenalidomide and dexamethasone for the treatment of newly diagnosed multiple myeloma.

Ahead of the 2014 ASH Annual Meeting & Exhibition we discuss current treatment strategies for elderly patients with acute myeloid leukemia.

Non-germinal center B-cell-like DLBCL patients derived the most benefit from treatment with the immunochemotherapy regimen R-ACVBP compared with R-CHOP.

Elderly patients with poor-prognosis DLBCL may derive the most benefit from treatment with extended rituximab plus 6 cycles of R-CHOP on a 14-day schedule.

A 48-year-old man presents with diffuse lymphadenopathy. After further evaluation, a biopsy is performed. What is your diagnosis?

Adding the HDAC inhibitor valproic acid to decitabine did not improve outcomes in patients with myelodysplastic syndromes or acute myeloid leukemia.

Hispanic childhood cancer survivors are less likely to receive follow-up care later in life than white survivors, according to a new study.

Survivors of multiple myeloma and pancreatic cancer may have some of the poorest physical health-related quality of life outcomes, according to a new study.

Patients who experienced early relapse of multiple myeloma after undergoing autologous stem cell transplantation had worse progression-free and overall survival.

Survivors of childhood Hodgkin lymphoma who went on to regularly complete vigorous exercise had a lower risk of cardiovascular events later in life.

Ninety percent of patients with relapsed/refractory acute lymphoblastic leukemia achieved complete remission after a T-cell therapy treatment targeting CD19.
Monitoring minimal residual disease and real-time quantitative polymerase chain reaction can predict relapse in pediatric acute lymphoblastic leukemia patients.

A phase III trial of vosaroxin failed to meet its primary overall survival endpoint in patients with first relapsed or refractory acute myeloid leukemia.

Myeloma patients treated with melphalan prior to transplant had reductions in chemo-induced nausea/vomiting when given granisetron/dexamethasone and aprepitant.